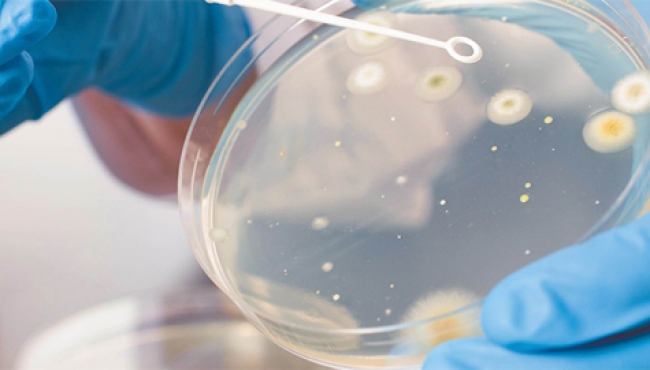
Premian a mexicanas por sus investigaciones sobresalientes en microbiología

Premian a mexicanas por sus investigaciones sobresalientes en microbiología
La Universidad Nacional Autónoma de México (UNAM) destacó que el objetivo del galardón que otorgan de manera conjunta la UNAM y la Asociación Americana de Microbiología (ASM, por sus siglas en inglés), y que se entrega por primera vez, es estimular el desarrollo en el área.
El docente de la ENES Morelia, Luis Eduardo Servín Garcidueñas y joven embajador de Ciencias de la ASM, la organización más grande en la promoción del avance y difusión de los estudios microbiológicos, fue quien propuso este reconocimiento y gestionó su entrega.
Emily García, estudiante de la licenciatura en Ciencias Ambientales (LCA), fue distinguida por el proyecto “Diversidad funcional microbiana asociada al ciclo del fósforo en encinares templados del centro de México”, con la asesoría de Yunuen Torres Tapia, académica de la entidad multidisciplinaria.
Mientras que por el mejor cartel se premió a Dania Alcántar, con la investigación “Contribución de la simbiosis micorrízica en la nutrición de maíz en suelo con baja disponibilidad de fósforo”, con la tutoría de John Larsen y Dante López Carmona, investigadores del Instituto de Investigaciones en Ecosistemas y Sustentabilidad (IIES) de esta casa de estudios.
La premiación se llevó a cabo durante la Jornada de Estancias Académicas de la LCA, en donde 80 alumnos de octavo semestre expusieron carteles informativos y presentaciones de sus áreas de estudio: manejo de sistemas socioecológicos, sociedad y ambiente, y ecotecnologías.(NOTIMEX)]












En… Redes Sociales